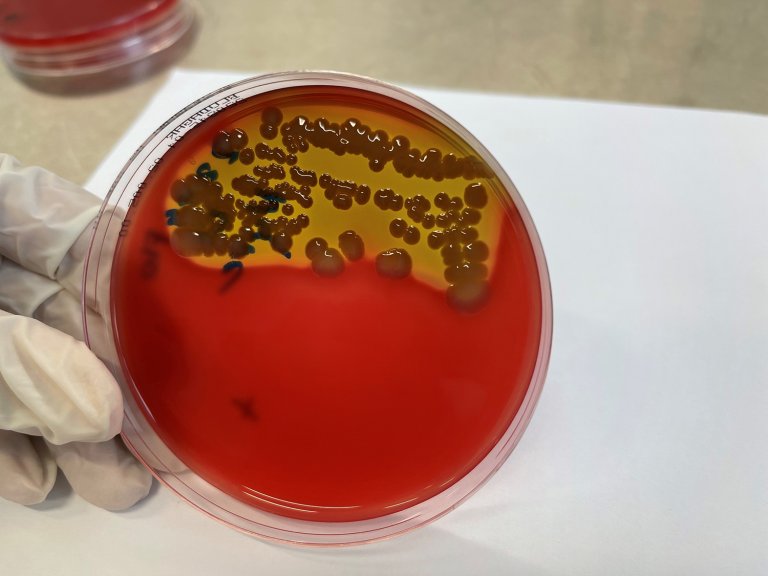
Vekst av Vibrio anguillarum fra villaks i Lysakerelva. Foto: Duncan Colquhoun, Veterinærinstituttet

Klassisk vibriose hos villaks i Lysakerelva
Veterinærinstituttet har påvist sykdommen klassisk vibriose på død villaks funnet i Lysakerelva i Oslo. Dette er et svært uvanlig funn.
Veterinærinstituttet ble kontaktet den 22. august om sykdom hos villaks i Lysakerelva i Oslo/Bærum. Samtidig ble det rapportert om syke og døde flyndrer ved utløpet av elva. I samarbeid med grunneierlaget er tre laks undersøkt ved Veterinærinstituttet. På alle tre vokste det rikelig med bakterien Vibrio anguillarum, bakterien som gir sykdommen «klassisk» vibriose.
- Dødelighet som følge av infeksjoner med denne bakterien hos vill laks er så langt vi vet ikke beskrevet tidligere, sier Åse Helen Garseth, fagansvarlig for villfiskhelse i Veterinærinstituttet. Veterinærinstituttet har varslet Mattilsynet og informert Statsforvalteren og elveeierlag om hendelsen.
Avkrefter red skin disease
Sår og rødhet i hud er vanlige funn ved vibriose. Infeksjonen kan dermed ha likhetstrekk med sykdommen red skin disease. Årsaken til red skin disease er fortsatt ukjent, men undersøkelser gjennomført av Veterinærinstitutter tyder ikke på at infeksjon er en primærårsak
Klassisk vibriose forekommer hos mange forskjellige fiskearter i hele verden, både vill fisk og fisk i oppdrett i sjø eller brakkvann, gjerne i perioder med spesielt høy vanntemperatur.
Vibriose er hovedsakelig forbundet med alvorlig sykdom hos vill marin fisk, for eksempel sei, og i oppdrettet regnbueørret, laks, torsk, leppefisk og rognkjeks. I Norge er oppdrettslaksen stort sett vaksinert mot vibriose, og er derfor godt beskyttet.
Laksen i Lysakerelva er ifølge grunneierlaget kjent for å oppholde seg en periode i fjorden og gå sent opp i elva. Siden laksen smittes i sjø, vil faktorer som forlenger oppholdet i sjøen kunne øke smittefaren. Lav vannstand i elva kan forsinke oppgangen av laksen ytterligere og det kan gi høyere fisketetthet ved utløpet av elva og større sannsynlighet for spredning av smitte.
Ber publikum melde ifra om sykdom og dødelighet
Veterinærinstituttet har i samarbeid med Mattilsynet opprettet en meldingstjeneste der publikum og elveeierlag kan varsle om sykdom og dødelighet i vassdrag. Denne ligger i syk villfisk portalen
Også sykdom i Akerselva
Det er også registrert laks med lignende sykdomstegn i Akerselva og Veterinærinstituttet har mottatt villaks for obduksjon og videre undersøkelser.
Smittespredning og kontrolltiltak
V. anguillarum er en vanlig bakterie i sjøvann og brakkvann. Når smitten etablerer seg i en fiskepopulasjon kan bakterien oppformeres i fisken med påfølgende økende smittepress og utvikling av sjukdom. I Norsk oppdrett av laks og regnbueørret har vaksinasjon god effekt. Vaksinasjon av marine fiskearter er også vanlig og har god effekt, selv om effekten ikke er så god som hos laksefisk.
For villfiskens vedkommende vil vannstand i elvene ha betydning for smittepress, oppholdstid i brakkvann og sjø. Her kan også skader, for eksempel forårsaket av lakselus være en utfordring. De generelle rådene for å unngå videre spredning av smitte i ferskvann er:
- Unngå å flytte fisk fra ett vassdrag til et annet
- Desinfiser og tørk fiskeutstyr, vadere, håver og annet utstyr før flytting mellom vassdrag
- Syk eller medtatt fisk bør ikke settes ut igjen i vassdrag, men deponeres på egnet plass
Vibrio anguillarum smitter primært fisk, krepsdyr og skjell. Sykdom hos mennesker med nedsatt immunforsvar er likevel beskrevet. Fisk med vibriose kan fremstå både uappetittlig og uegnet som menneskemat, og bør uansett varmebehandles. Det kan ikke utelukkes at katt og hund som spiser syk fisk får symptomer fra mage og tarm. Pattedyr, som mink og oter, og fugl kan bidra til å spre smitte ved å flytte med seg fisk.

